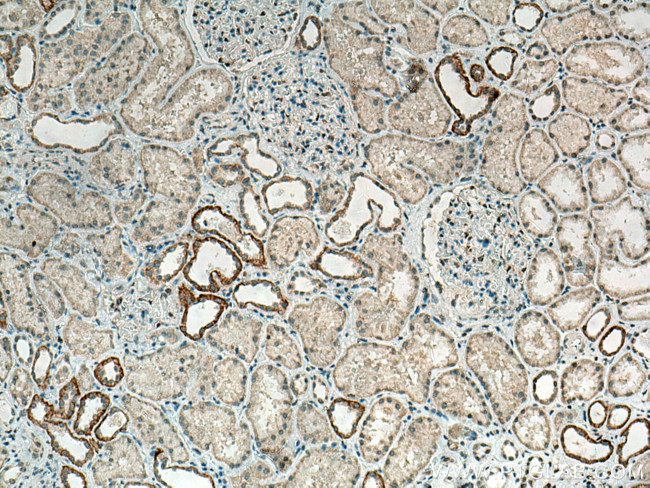
CLCNKA Antibody in Immunohistochemistry (Paraffin) (IHC (P))
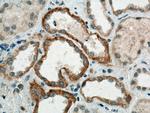
CLCNKA Antibody in Immunohistochemistry (Paraffin) (IHC (P))

Search
Proteintech
CLCNKA Polyclonal Antibody
{{$productOrderCtrl.translations['antibody.pdp.commerceCard.promotion.promotions']}}
{{$productOrderCtrl.translations['antibody.pdp.commerceCard.promotion.viewpromo']}}
{{$productOrderCtrl.translations['antibody.pdp.commerceCard.promotion.promocode']}}: {{promo.promoCode}} {{promo.promoTitle}} {{promo.promoDescription}}. {{$productOrderCtrl.translations['antibody.pdp.commerceCard.promotion.learnmore']}}
产品信息
14402-1-AP
种属反应
宿主/亚型
分类
类型
抗原
偶联物
形式
浓度
规格
纯化类型
保存液
内含物
保存条件
运输条件
产品详细信息
Immunogen sequence: CQPSFYDGT IIVKKLPYLP RILGRNIGSH HVRVEHFMNH SITTLAKDTP LEEVVKVVTS TDVTEYPLVE STESQILVGI VQRAQLVQAL QAEPPSRAPG HQQCLQDILA RGCPTEPVTL TLFSETTLHQ AQNLFKLLNL QSLFVTSRGR AVGCVSWVEM KKAISNLTNP PAPK (515-687 aa encoded by B C048282)
靶标信息
CLC-KA is a kidney-specific chloride channel that mediates transepithelial chloride transport in the thin ascending limb of the Henle loop in the inner medulla. CLC-KA plays a crucial role in urine concentration. The gene encoding human CLC-KA maps to chromosome 1p36. Mutations in this gene may be associated with nephrogenic diabetes insipidus in those cases where mutations in the vasopressin V2 receptor and the AQP2 water channel are lacking. CLC-KB mediates basolateral chloride ion efflux in the thick ascending limb and in more distal nephron segments. The gene encoding human CLC-KB maps to chromosome 1p36. Mutations in this gene cause type III Barter's syndrome which is characterized by renal salt-wasting and low blood pressure.
仅用于科研。不用于诊断过程。未经明确授权不得转售。
篇参考文献 (0)
生物信息学
蛋白别名: chloride channel K1; Chloride channel Ka; Chloride channel protein ClC-Ka; chloride channel, kidney, A; chloride channel, voltage-sensitive Ka; ClC-K1; CLC-KA; CLCKA; putative basolateral cTAL chloride channel ClC-Ka; unnamed protein product
基因别名: C75963; CLC-K1; CLCK1; Clcnk1; CLCNKA; hClC-Ka
UniProt ID: (Human) P51800, (Mouse) A2ADB3, (Rat) Q06393
Entrez Gene ID: (Human) 1187, (Mouse) 12733, (Rat) 79425